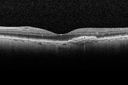
amd_heme_jste_071415_30.jpg

Bilateral new wet AMD with subretinal hemorrhage
|
|
84 year old man with poor recent vision loss in left eye from a subretinal hemorrhage. Vision is 3/200 in the right eye and 20/40 in the left eye. Vision in the left eye improved to 20/25 with treatment with Eylea
|

New wet AMD OS with subretinal hemorrhage and recent vision loss, Scar OD611 views     (0 votes)
|
|

New wet AMD OS with subretinal hemorrhage and recent vision loss, Scar OD514 views     (0 votes)
|
|

New wet AMD OS with subretinal hemorrhage and recent vision loss, Scar OD464 views     (0 votes)
|
|

New wet AMD OS with subretinal hemorrhage and recent vision loss, Scar OD436 views     (0 votes)
|
|

New wet AMD OS with subretinal hemorrhage and recent vision loss, Scar OD433 views     (0 votes)
|
|

New wet AMD OS with subretinal hemorrhage and recent vision loss, Scar OD422 views     (0 votes)
|
|

New wet AMD OS with subretinal hemorrhage and recent vision loss, Scar OD476 views     (0 votes)
|
|

New wet AMD OS with subretinal hemorrhage and recent vision loss, Scar OD479 views     (0 votes)
|
|

New wet AMD OS with subretinal hemorrhage and recent vision loss, Scar OD476 views     (0 votes)
|
|

New wet AMD OS with subretinal hemorrhage and recent vision loss, Scar OD449 views     (0 votes)
|
|

New wet AMD OS with subretinal hemorrhage and recent vision loss, Scar OD430 views     (0 votes)
|
|

New wet AMD OS with subretinal hemorrhage and recent vision loss, Scar OD410 views     (0 votes)
|
|

New wet AMD OS with subretinal hemorrhage and recent vision loss, Scar OD404 views     (0 votes)
|
|

New wet AMD OS with subretinal hemorrhage and recent vision loss, Scar OD430 views     (0 votes)
|
|

New wet AMD OS with subretinal hemorrhage and recent vision loss, Scar OD409 views     (0 votes)
|
|

New wet AMD OS with subretinal hemorrhage and recent vision loss, Scar OD374 views     (0 votes)
|
|

New wet AMD OS with subretinal hemorrhage and recent vision loss, Scar OD383 views     (0 votes)
|
|

New wet AMD OS with subretinal hemorrhage and recent vision loss, Scar OD434 views     (0 votes)
|
|

New wet AMD OS with subretinal hemorrhage and recent vision loss, Scar OD421 views     (0 votes)
|
|

New wet AMD OS with subretinal hemorrhage and recent vision loss, Scar OD388 views     (0 votes)
|
|

New wet AMD OS with subretinal hemorrhage and recent vision loss, Scar OD419 views     (0 votes)
|
|
Wet AMD 1 month after Eylea - macula is dry and vision is better448 views     (0 votes)
|
|

Wet AMD 1 month after Eylea - macula is dry and vision is better465 views     (0 votes)
|
|
|
|
|
84 year old man with poor recent vision loss in left eye from a subretinal hemorrhage. Vision is 3/200 in the right eye and 20/40 in the left eye. Vision in the left eye improved to 20/25 with treatment with Eylea